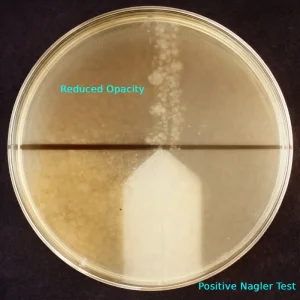

Nagler Reaction Test: Principle, Procedure & Interpretation
The Nagler reaction, also known as the Nagler test, is a classical yet clinically significant phenotypic laboratory test used for the identification and confirmation of Clostridium perfringens based on its ability to produce lecithinase C (alpha toxin). The test relies on the neutralization of lecithinase activity by a specific antitoxin, …